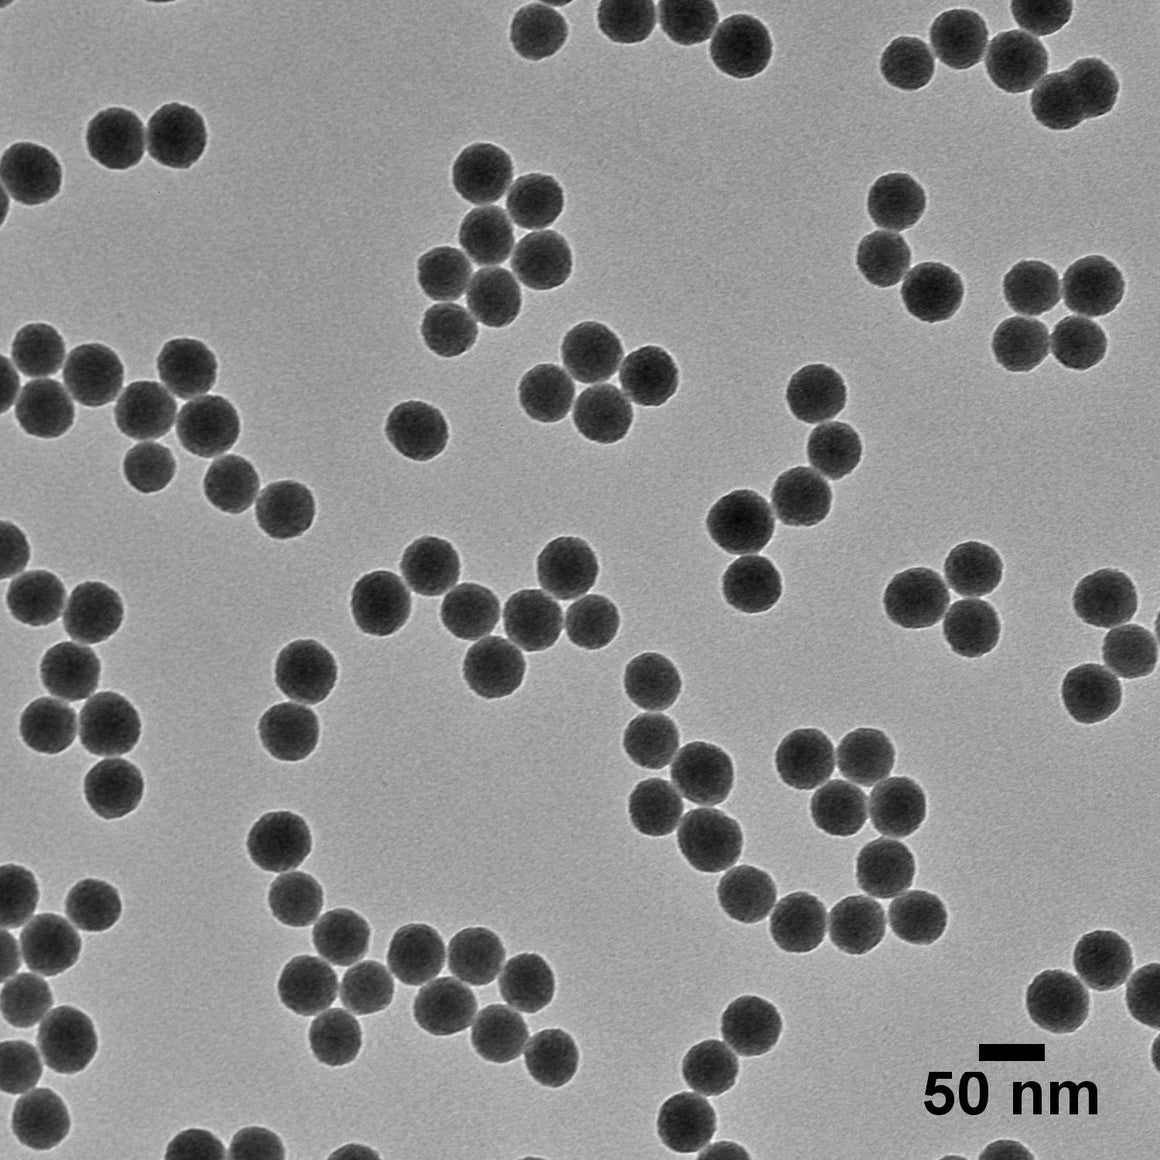

nanocomposix NanoXact二氧化矽納米球說明書(shu) ·sms
具有裸露表麵(標準)的二氧化矽納米球是單分散的,直徑為(wei) 20 nm以上。了解更多 ❯
NanoXact材料是高質量,無團聚和單分散的納米顆粒。了解更多 ❯
對於(yu) 20 nm的顆粒,以5 mg / mL的濃度提供;對於(yu) 所有其他尺寸的水溶液,以10 mg / mL的濃度提供。

| TEM直徑 | 尺寸分布(CV) |
|---|---|
| 20納米±4納米 | ≤15% |
| 50納米±4納米 | ≤12% |
| 60納米±4納米 | ≤12% |
| 80納米±4納米 | ≤12% |
| 100納米±4納米 | ≤12% |
| 120納米±4納米 | ≤12% |
| 200納米±10納米 | ≤12% |
| 300納米±30納米 | ≤12% |
| 500納米±50納米 | ≤5% |
| 1000納米±50納米 | ≤5% |
注意:以下近似範圍取決(jue) 於(yu) 直徑
電話
QQ掃一掃

